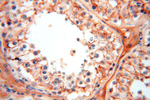
FXYD6 Antibody in Immunohistochemistry (Paraffin) (IHC (P))

Search
Proteintech
FXYD6 Polyclonal Antibody
{{$productOrderCtrl.translations['antibody.pdp.commerceCard.promotion.promotions']}}
{{$productOrderCtrl.translations['antibody.pdp.commerceCard.promotion.viewpromo']}}
{{$productOrderCtrl.translations['antibody.pdp.commerceCard.promotion.promocode']}}: {{promo.promoCode}} {{promo.promoTitle}} {{promo.promoDescription}}. {{$productOrderCtrl.translations['antibody.pdp.commerceCard.promotion.learnmore']}}
产品信息
15805-1-AP
种属反应
宿主/亚型
分类
类型
抗原
偶联物
形式
浓度
规格
纯化类型
保存液
内含物
保存条件
运输条件
产品详细信息
Immunogen sequence: KEKEMDPFH YDYQTLRIGG LVFAVVLFSV GILLILSRRC KCSFNQKPRA PGDEEAQVEN LITANATEPQ KAEN (23-95 aa encoded by BC018652)
靶标信息
This gene encodes a member of the FXYD family of transmembrane proteins. This particular protein encodes phosphohippolin, which likely affects the activity of Na,K-ATPase. Multiple alternatively spliced transcript variants encoding the same protein have been described. Related pseudogenes have been identified on chromosomes 10 and X. Read-through transcripts have been observed between this locus and the downstream sodium/potassium-transporting ATPase subunit gamma (FXYD2, GeneID 486) locus.
仅用于科研。不用于诊断过程。未经明确授权不得转售。
生物信息学
蛋白别名: FXYD domain-containing ion transport regulator 6; FXYD6; Phosphohippolin; PLM-like protein; unnamed protein product; Vascular endothelial cell-specific protein 6; VESP6
基因别名: 0610030I18Rik; FXYD6; Php; Plp; UNQ521/PRO1056
UniProt ID: (Human) Q9H0Q3, (Mouse) Q9D164, (Rat) Q91XV6
Entrez Gene ID: (Human) 53826, (Mouse) 59095, (Rat) 63847